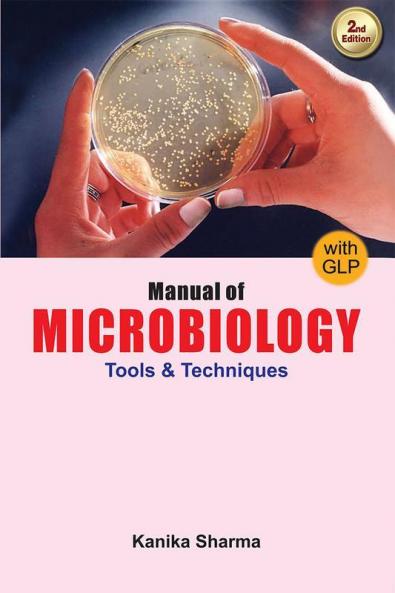

English
Paperback
₹542
₹695
22.01% OFF
(All inclusive*)
Delivery Options
Please enter pincode to check delivery time.
*COD & Shipping Charges may apply on certain items.
Review final details at checkout.
Looking to place a bulk order? SUBMIT DETAILS
Delivery Options
Please enter pincode to check delivery time.
*COD & Shipping Charges may apply on certain items.
Review final details at checkout.
About The Book
Description
Author
This book is an excellent supplementary textbook written in simple language and easy to understand even for beginners. All topics related to microbiology are covered-general aspects like techniques culture and identification of bacteria bacterial genetics water soil and food microbiology and the study of viruses and fungi. medical microbiology is also discussed dealing with sample collection and identification of common pathogenic bacteria. The book has a unique style-a basic idea of the topic is given followed by various laboratory methods presented systematically keeping in mind problems faced by students and also stressing the ''do''s and don''ts'' while carrying out various experiments. Diagrams and flow charges help to make learning easier and more interesting. And final chapters contain instructions on practical exercises written to enable the student to perform them with confidence and ease. This is a superb step-by-step guide for microbiology students. Also Basic Research & Applications of Mycorrhizae (Microbiology Series) - ISBN 1904798489Biotechnological Applications of Microbes (Microbiology Series) - ISBN 1904798616
Details
ISBN 13
9788180521430
Publication Date
-05-10-2019
Pages
-460
Weight
-648 grams
Dimensions
-155.96x233.93x24.23 mm
Imprint
-Ane Books Pvt Ltd